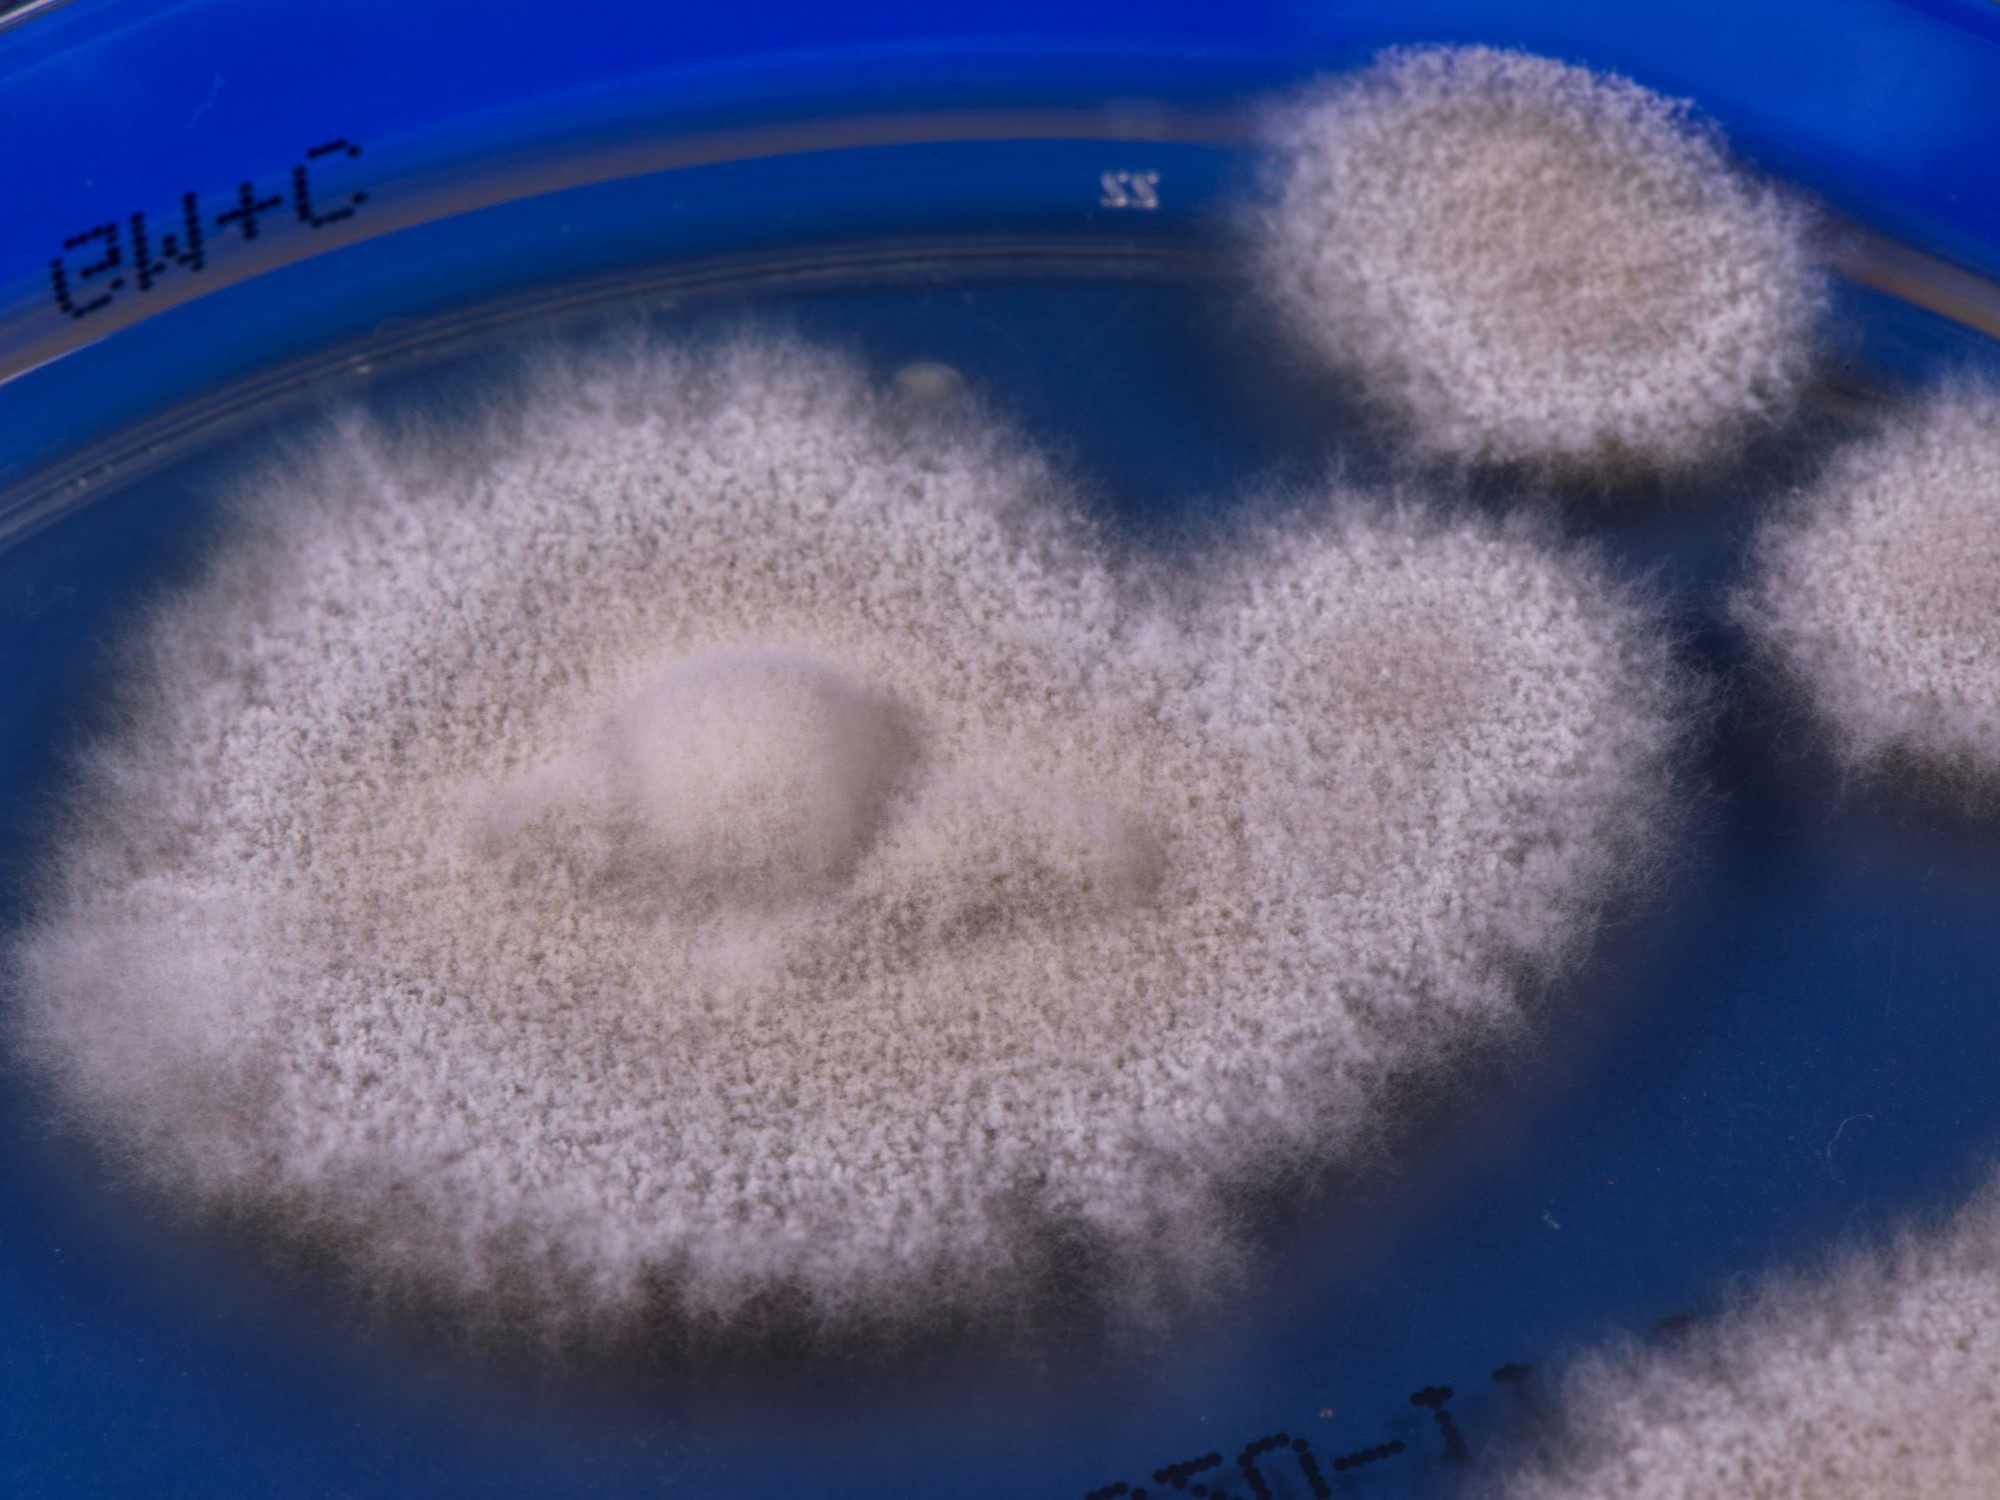
LABOPART Trichophyton indotineae

Indotyphlops tenuicollis est une espèce de serpents de la famille des Typhlopidae.
Répartition
Cette espèce est endémique des Naga Hills dans l'État du Nagaland en Inde.
Publication originale
- Peters, 1864 : Über neue Amphibien (Typhloscincus, Typhlops, Asthenodipsas, Ogmodon). Monatsberichte der Königlichen Preussischen Akademie der Wissenschaften zu Berlin, vol. 1864, p. 271-276 (texte intégral).
Liens externes
- (en) Animal Diversity Web : Typhlops tenuicollis (consulté le )
- (en) Catalogue of Life : Typhlops tenuicollis (Peters, 1864) (consulté le )
- (fr en) ITIS : Typhlops tenuicollis (Peters, 1864) (consulté le )
- (en) Reptarium Reptile Database : Indotyphlops tenuicollis (Peters, 1864) (consulté le )
- (en) UICN : espèce Typhlops tenuicollis (Peters, 1864) (consulté le )
Notes et références
- Portail de l’herpétologie
- Portail de l’Inde